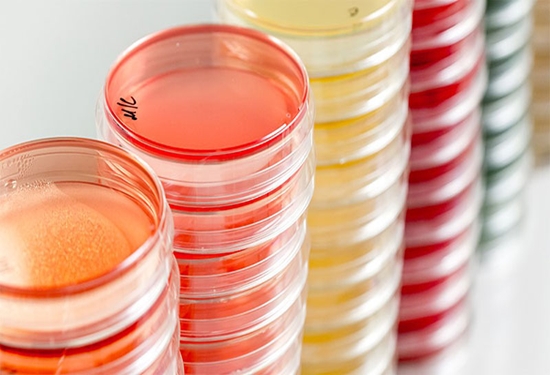

تأیید توان آزمایشگاهی دامپزشکی سیستان و بلوچستان برای صیانت از غذای مردم
آزمایشگاه مرکزی ادارهکل دامپزشکی سیستان و بلوچستان در ارزیابی کشوری آزمایشگاههای دامپزشکی، موفق به دریافت گواهی آزمون مهارت (Proficiency Testing) در زمینه جستجوی سالمونلا در مواد غذایی شد؛ گواهیای که نقش مهمی در تأیید سلامت و امنیت غذایی جامعه دارد.
به گزارش روابط عمومی ادارهکل دامپزشکی سیستان و بلوچستان، روحالله زینلی، مسئول آزمایشگاه مرکزی این ادارهکل اظهار کرد: این آزمون مهارت در حوزه میکروبی مواد غذایی و با مشارکت آزمایشگاههای ادارات کل دامپزشکی استانهای کشور، توسط مرکز ملی تشخیص، آزمایشگاههای مرجع و مطالعات کاربردی سازمان دامپزشکی کشور برگزار شد.
وی افزود: آزمایشگاه مرکزی دامپزشکی سیستان و بلوچستان با اتکا به توان علمی کارشناسان متخصص، رعایت الزامات فنی و استانداردهای تخصصی و بهرهگیری از تجهیزات و زیرساختهای موجود، موفق به کسب نتایج مطلوب و دریافت گواهی آزمون مهارت در جستجوی سالمونلا شد.
مسئول آزمایشگاه مرکزی دامپزشکی استان با قدردانی از حمایتها و رهنمودهای ارزشمند مرکز ملی تشخیص، آزمایشگاههای مرجع و مطالعات کاربردی، گفت: آزمونهای مهارت با هدف ارزیابی دقت و صحت نتایج آزمایشگاهی، اطمینان از عملکرد صحیح روشهای آزمون، کنترل کیفیت داخلی و خارجی و بهروز بودن فرآیندهای کالیبراسیون تجهیزات برگزار میشود.
زینلی ادامه داد: شناسایی نقاط قابل بهبود در فرآیندهای آزمون، ارتقای دانش و مهارت نیروی انسانی، مقایسه توانمندیهای فنی آزمایشگاهها، پاسخگویی به الزامات مراجع قانونی و نهادهای تأیید صلاحیت و افزایش اعتماد مصرفکنندگان از مهمترین دستاوردهای شرکت در آزمونهای مهارت به شمار میرود.
وی با تأکید بر اهمیت کنترل عوامل بیماریزای منتقله از غذا، بهویژه سالمونلا، خاطرنشان کرد: استمرار حضور موفق در ارزیابیهای ملی و تخصصی، گامی مؤثر در راستای تضمین سلامت مواد غذایی با منشأ دامی، پیشگیری از بیماریهای مشترک بین انسان و دام و ارتقای جایگاه آزمایشگاههای دامپزشکی سیستان و بلوچستان در سطح کشور است.






نظر دهید